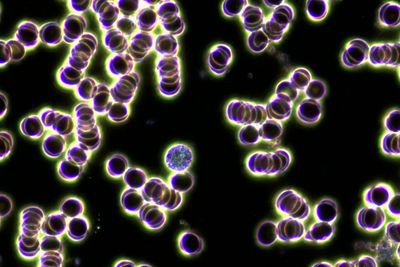

We may regularly go to our doctor and get regular blood tests done but these tests only give us part of the information that we need to understand our health.
Blood Behaviour Analysis is an exciting modality where a drop of blood is taken from a finger tip and placed under a very powerful microscope for the practitioner to view. The blood sample is viewed under 2 different filters which highlight blood cell features that are difficult to see under normal bright field analysis. Your BBA practitioner is trained to observe the behaviour of blood from the actual taking of the blood right through to 30 mins post blood taking. This gives a fascinating view into the world of blood that is the lifeline to your body and health.
BBA looks at the behaviour of white blood cells, red blood cells, quality of blood components and picks up anything unusual that can point your practitioner to have insight and direction into health issues that can be investigated with other modalities.
During a consult, you will be able to view your blood on screen and learn how this mysterious world works in your body.
This consultation takes longer than a standard consultation so make sure to book under 'Blood Behaviour Analysis' to ensure that you have the correct amount of time assigned.
We use cookies to analyze website traffic and optimize your website experience. By accepting our use of cookies, your data will be aggregated with all other user data.